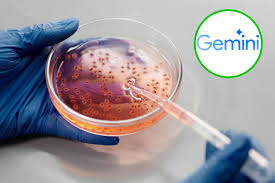

16 de junio del 2025 “ La Universidad Autónoma de Tamaulipas (UAT) informa que a partir de este lunes 16 de junio se encuentra abierto el... Read More
Mes: junio 2025
15 de junio del 2025 “ La Universidad Autónoma de Tamaulipas (UAT) presentó el nuevo Portal de Producción Científica, una plataforma digital desarrollada para fortalecer la... Read More
14 de junio del 2025 “ Una noche histórica se vivió este sábado en el Gimnasio Multidisciplinario de la Universidad Autónoma de Tamaulipas, donde la pasión... Read More
Reynosa, Tamaulipas.- El gobernador Américo Villarreal Anaya hizo un reconocimiento a la relación colaborativa y solidaria que el Gobierno del Estado ha recibido de las... Read More
13 de junio del 2025 “ La Universidad Autónoma de Tamaulipas (UAT) obtuvo destacadas distinciones en diversas categorías y áreas de conocimiento durante la ceremonia de... Read More
El Pleno de la Comisión Federal de Competencia Económica (Cofece) determinó el cierre del procedimiento seguido contra el gigante tecnológico Google en el mercado de... Read More
Un problema complejo que los microbiólogos tardaron una década en resolver se ha resuelto en tan solo dos días gracias a una nueva herramienta de... Read More
12 de junio del 2025 “ El rector de la Universidad Autónoma de Tamaulipas (UAT), Dámaso Anaya Alvarado, sostuvo una reunión con un grupo de investigadoras... Read More
11 de junio del 2025 “ El equipo Correcaminos Sub-17 de la Universidad Autónoma de Tamaulipas (UAT) se consagró campeón regional de la Liga Nacional Juvenil,... Read More
11 de junio del 2025 “ El rector de la Universidad Autónoma de Tamaulipas (UAT), Dámaso Anaya Alvarado, recibió al titular de la Secretaría de Desarrollo... Read More

 Abre la UAT convocatoria de becas para el período 2025-3
Abre la UAT convocatoria de becas para el período 2025-3  Presenta la UAT nuevo Portal de Producción Científica
Presenta la UAT nuevo Portal de Producción Científica  En un juego épico de playoffs Correcaminos UAT Femenil pierde la serie ante Fuerza Regia
En un juego épico de playoffs Correcaminos UAT Femenil pierde la serie ante Fuerza Regia  Reconoce Américo respaldo de las Fuerzas Armadas en Tamaulipas
Reconoce Américo respaldo de las Fuerzas Armadas en Tamaulipas  Premian proyectos de la UAT en la Feria de Ciencias e Ingenierías Tamaulipas 2025
Premian proyectos de la UAT en la Feria de Ciencias e Ingenierías Tamaulipas 2025  Cofece cierra caso contra Google por presuntas prácticas monopólicas
Cofece cierra caso contra Google por presuntas prácticas monopólicas El problema sobre superbacterias que tomó años para ser resuelto por los científicos y que la IA solucionó en dos días
El problema sobre superbacterias que tomó años para ser resuelto por los científicos y que la IA solucionó en dos días  Organiza la UAT el VI Congreso de Investigadoras del SNII y de Iberoamérica
Organiza la UAT el VI Congreso de Investigadoras del SNII y de Iberoamérica  Correcaminos UAT Sub-17 conquista torneo regional y avanza al nacional juvenil de la FEMEXFUT
Correcaminos UAT Sub-17 conquista torneo regional y avanza al nacional juvenil de la FEMEXFUT  Reafirma la UAT colaboración en la agenda energética de Tamaulipas
Reafirma la UAT colaboración en la agenda energética de Tamaulipas  Reconoce el gobernador Américo Villarreal estándares de excelencia de la UAT
Reconoce el gobernador Américo Villarreal estándares de excelencia de la UAT  Reconoce Dámaso Anaya labor docente como pilar en la transformación de la UAT
Reconoce Dámaso Anaya labor docente como pilar en la transformación de la UAT  Festejan a maestros de Familia UAT
Festejan a maestros de Familia UAT  Confiere la UAT Doctorado Honoris Causa al secretario de Saludfederal David Kershenobich
Confiere la UAT Doctorado Honoris Causa al secretario de Saludfederal David Kershenobich